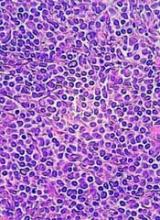

Long-term results of a phase 2 clinical trial of the lenalidomide and rituximab combination as first-line therapy for mantle cell lymphoma (MCL) show continued durable responses with manageable toxicities after 5 years.
With a median follow-up of 64 months, 21 of 33 patients with initial responses remained in durable, minimal residual disease (MRD)-negative remission following induction with lenalidomide and rituximab and maintenance with those same two agents for at least 3 years.
The patients with durable responses included five who opted to discontinue maintenance after 3 years, reported Jia Ruan, MD, PhD, of Cornell University in New York, and her colleagues.
“Our long-term data provide proof of concept that an outpatient-based induction and maintenance strategy free of conventional chemotherapy is effective, safe, and feasible as first-line therapy for MCL,” they wrote.
Their report was published in Blood.
In the multicenter, phase 2 single-arm study (NCT01472562), 38 patients with untreated MCL were enrolled and treated with lenalidomide 20 mg daily on days 1-21 of each 28-day cycle for 12 cycles during induction, followed by dose reduction to 15 mg during the maintenance phase.
Patients also received standard dose rituximab 375 mg/m2 weekly for 4 weeks during cycle 1, then once every other cycle.
Patients remained on treatment until disease progression, unacceptable toxicities, or study withdrawal. Patients who remained in remission after 3 years, based on routine surveillance CT scans, had the option to discontinue maintenance.
Results
Of the original 38 patients enrolled, 36 were evaluable for response, including 23 with a complete response (CR) and 10 with a partial response.
At the 64-month median follow-up, neither the median progression-free survival (PFS) nor duration of response had been reached.
Overall, 21 of the 33 patients with responses (64%) had ongoing responses, including six patients with responses beyond 6 years.
Estimated 3-year and 5-year PFS rates were 80.3% and 63.9%, respectively. Respective estimated 3- and 5-year overall survival rates were 89.5% and 77.4%.
Mantle cell lymphoma international prognostic index (MIPI) scores were not associated with either response or PFS rates, but patients with high-risk MIPI scores were significantly more likely to have worse overall survival (P=0.04).
Safety
Grade 3 or greater hematologic toxicities included neutropenia in 42% of patients in both induction and maintenance, anemia in 8% and 3%, thrombocytopenia in 11% and 5%, and febrile neutropenia in 3% and 5%.
Secondary primary malignancies occurred in six patients. These included five noninvasive skin cancers requiring only local therapy without the need for study interruption.
Two patients, including one with a skin cancer, died from the secondary malignancies, including one from Merkel cell carcinoma and one from pancreatic cancer.
“The efficacy and survival outcome observed in our study compared favorably to those reported with lenalidomide either as single agent, or in combination with rituximab in relapsed and refractory setting,” the investigators wrote, “lending support for prioritizing novel agents such as lenalidomide early in the treatment sequence, to compare to conventional chemotherapy-based approach.”
The study was supported in part by Celgene Corporation, a Clinical Translational Science Center grant, and the Lymphoma Foundation.